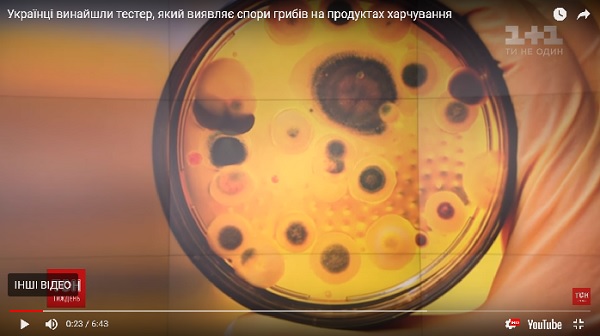

Дзьобак Володимир
РОЗДУМИ ПРО НАДВАЖЛИВЕ або ЧОМУ НАШІ ОЛІГАРХИ СТАЛИ МОГИЛЬЩИКАМИ НИНІШНЬОЇ УКРАЇНИ

Головним інструментом нинішніх олігархів є безправний люмпен, який живе на подачках від держави, на грані фізичного виживання. Ось чому значна частина пенсіонерів є найкращим їх електоратом, який і допомагає часто приводити до влади їх ставлеників. Для малого і середнього бізнесу сьогодні закриті економічні ліфти у цілих галузях економіки, бо з кожним роком сфери зацікавленості олігархії збільшуються, перекриваючи кисень усім іншим.